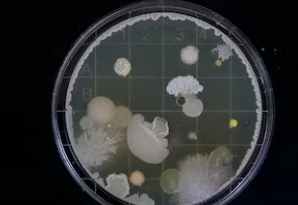

피부 상처 치료를 위해 사용되는 후시딘과 마데카솔은 겉보기에는 좀 비슷해 보이기도 합니다.
하지만, 효능과 차이점은 좀 많이 다를수 있습니다. 오늘은 후시딘과 마데카솔의 주요 성분과 작용 메커니즘, 그리고 각각의 효과에 대해 자세히 알아보겠습니다.

또한 두 연고의 사용법과 장단점을 비교하여 어떤 경우에 어떤 연고를 선택해야 하는지 알아봅시다.
후시딘과 마데카솔: 주요 성분과 어떨 때 사용해야할까요
후시딘은 '퓨시드나트륨'이라는 항생제 성분을 주요 성분으로 갖고 있습니다. 이 성분은 세균의 단백질 합성을 억제하여 세균의 증식을 방지하는 작용을 합니다.
후시딘은 주로 세균 감염을 억제하는 데에 효과적이며, 코리네박테륨, 클로스트리듐, 포도상구균, 연쇄구균에 특히 강력한 효과를 발휘합니다. 이로 인해 상처의 2차 감염을 예방하고 상처의 빠른 회복을 도와줍니다.

반면, 마데카솔은 '센텔라 아시아티카'라는 성분이 주를 이룹니다. 이 성분은 새살 형성과 피부 재생을 촉진하여 상처 치유를 돕는 작용을 합니다.
마데카솔은 주로 흉터를 관리하고 개선하는 데에 효과적이며, 피부와 비슷한 성분이기 때문에 얕은 상처나 피부 문제에 사용하는 것이 적합합니다.
항생제 성분이 없기 때문에 2차 감염을 예방하는 효과는 없지만, 이로 인해 아이들에게도 안전하게 사용할 수 있습니다.
후시딘과 마데카솔: 효과 비교
후시딘과 마데카솔은 각자의 특성과 효능에 따라 사용하는 경우가 다릅니다. 후시딘은 주로 세균 감염을 억제하는 항생제 성분이기 때문에 상처의 감염 예방과 빠른 치유에 탁월한 효과가 있습니다.


특히 깊은 상처 또는 산과 코로나 등의 감염 위험이 높은 상황에서 후시딘이 효과적입니다. 또한 코리네박테륨, 클로스트리듐, 포도상구균, 연쇄구균에 특히 강력한 효과를 발휘하여 감염 위험이 있는 피부 상태에 사용할 때 좋습니다.
반면, 마데카솔은 피부 재생을 돕고 흉터를 개선하는 데에 탁월한 성분으로 얕은 상처나 피부 문제에 사용하는 것이 적합합니다.
새살 형성에 도움이 되기 때문에 피부의 탄력을 높여주고, 기미와 주근깨 등의 색소 침착 문제에도 효과적입니다. 또한 항생제 성분이 없기 때문에 아이들에게도 안전하게 사용할 수 있습니다.
후시딘과 마데카솔 차이: 사용법은 어떻게 다를까?
후시딘과 마데카솔의 사용법은 유사합니다. 후시딘은 수용성 겔 타입이기 때문에 흡수력이 빠르며, 상처 부위를 소독한 뒤 면봉에 연고를 덜어서 바르면 됩니다. 아침과 저녁으로 얇게 발라주면 상처의 회복에 도움이 됩니다.



이 때, 항생제 성분에 과민 반응을 보이는 경우가 있으니 이상 반응이 나타나면 사용을 중지하고 전문가의 조언을 받아야 합니다.
마데카솔도 마찬가지로 아침과 저녁으로 1-2회 적당량을 발라주면 됩니다. 얕은 상처나 피부 문제에 사용하기에 적합하며, 피부에 살짝 끈적임이 있을 수 있습니다.
특히 신경을 써야 할 점은 분말 형태의 마데카솔을 사용할 경우 깊은 상처에는 적합하지 않을 수 있으며, 이 경우 겔 형태를 선택하는 것이 좋습니다.
후시딘과 마데카솔: 어떤 것을 선택해야 할까?
후시딘과 마데카솔은 각자의 장점과 용도에 따라 선택해야 합니다. 깊은 상처나 감염 위험이 높은 상황에서는 후시딘이 효과적이며, 코리네박테륨, 클로스트리듐, 포도상구균, 연쇄구균과 같은 감염 위험이 있는 피부 상태에 사용할 때도 좋습니다. 하지만 장기적으로 사용할 경우 내성이 생길 수 있으므로 주의가 필요합니다.

반면, 마데카솔은 얕은 상처나 피부 문제에 사용하기에 적합하며, 새살 형성을 돕기 때문에 피부의 탄력을 높여주고 기미와 주근깨 등의 색소 침착 문제에도 효과적입니다. 또한 항생제 성분이 없기 때문에 어린이나 민감한 피부에도 안전하게 사용할 수 있습니다.

따라서, 후시딘과 마데카솔은 각자의 특성과 효능에 따라 사용 시기와 목적에 맞게 선택하여 사용하는 것이 중요합니다. 상처의 종류와 상태, 피부의 상태 등을 고려하여 올바른 선택을 하여 피부 상처를 효과적으로 치료하고 관리하는데 도움이 되기를 바랍니다.
'알아두면 유용한 건강 정보 & 시사경제 > 건강정보' 카테고리의 다른 글
| A형 독감 증상 잠복기 전염 등 독감 관련 내용 총정리 (0) | 2023.12.07 |
|---|---|
| 마이코플라즈마 폐렴 원인 증상 치료법 (0) | 2023.11.28 |
| 7월 제철음식, 여름 제철과일 총정리 (0) | 2023.06.24 |
| 루게릭병 초기증상 및 원인 총정리 (ALS: 근위축성 측삭 경화증) (0) | 2023.05.29 |
| 구획증후군 증상 및 원인 총정리 (0) | 2023.05.29 |
댓글